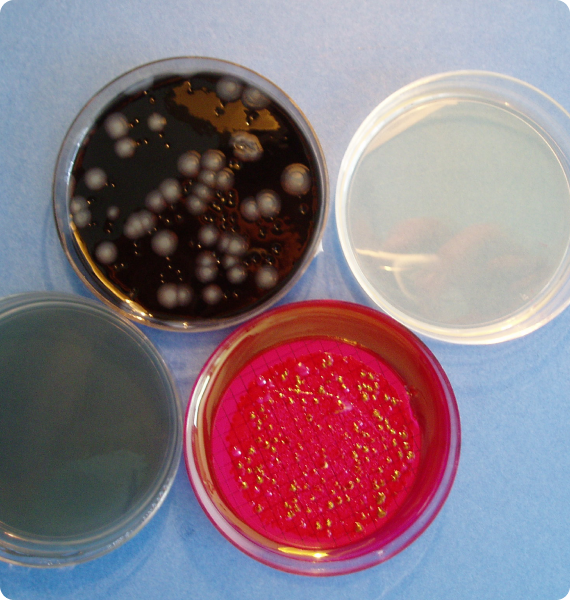

CONTATTACI PER UNA CONSULENZA

sicurezza e igiene alimentare
Siamo qualificati per garantire il rispetto di norme, standard igienici e formazione del personale. Offriamo un servizio completo di consulenza HACCP per aziende alimentari: dall’analisi in laboratorio alla documentazione, garantendo qualità e sicurezza attraverso un approccio preventivo.

Sicurezza alimentare
Con il nostro servizio di consulenza affianchiamo le aziende nella verifica della corretta applicazione pratica dell’autocontrollo relativamente all’operatività degli addetti durante le produzioni, all’igiene ambientale e personale, alla verifica della formazione con interviste in produzione, all’applicazione del piano prevenzione infestanti, alle corrette prassi igieniche della produzione, alla corretta predisposizione delle registrazioni HACCP.
I nostri tecnici si occuperanno inoltre di effettuare campionamenti microbiologici su superfici e alimenti durante le diverse fasi di lavorazione, mentre il nostro laboratorio accreditato effettuerà le analisi. Completano la nostra offerta specifici corsi di formazione per dipendenti e responsabili dell’industria alimentare.
- Autocontrollo e HACCP;
- Valutazione rischio Legionella;
- Valutazione rischio biologico;
- Piani di prevenzione contro specie parassite e infestanti.
Siamo a tua disposizione per capire le tue esigenze
e valutare insieme i servizi più adatti
